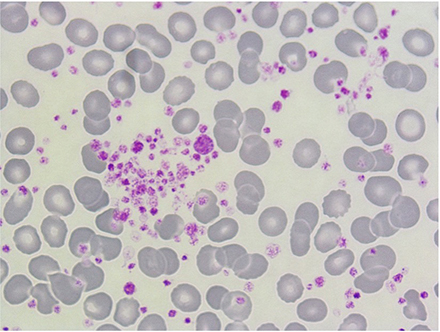
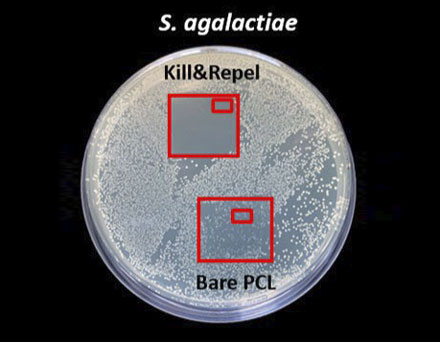

Consortium
Expertise and Role
Istituto Italiano di Tecnologia - IIT (Coordinator)
Fondazione Istituto Italiano di Tecnologia (IIT – Italian Institute of Technology,) is a scientific research center established by law in 2003, in order to promote excellence in both basic and applied research and to facilitate the economic development at national level. IIT scientific activities started in 2006, they are multidisciplinary and with a very strong approach to technology transfer. IIT staff is of more than 1900 people, the majority of which (about 81%) is dedicated to research, with an average age of 35 years (see https://www.iit.it/it/iit-numeri ). Research is carried out in the Central Research laboratory in Genoa (IIT headquarters IIT-HQ), in 14 research satellite centers across Italy. IIT scientific vision is interdisciplinary, and the main goal is to produce technologies that will have a positive impact on some important societal challenges, such as sustainability and the environment, healthcare and aging society, also reflecting the priorities of EU framework programs. IIT participate to the IV-Lab project with three different research groups, as follow.
IIT - Center for Materials Interfaces (CMI)
The Soft Micro-Electronic Materials Group in the Center for Materials Interfaces (CMI), located in Pontedera (PI), conducts its research in the field of materials science and technologies, focusing on the development of soft electronics devices and smart interfaces with advanced functionalities. The research of the group is primarily divided into two main areas: functional microfabrication, which involves the creation of microstructures and interfaces with functional materials, and soft electronics where ultra-thin conformable functional systems and their integration on the human skin (tattoo electronics) or other complex surfaces is studied, toward the realization of personal unperceivable healthcare monitoring devices, active tattoos, and electrically controllable drug delivery systems.
Key Contribution
Key People



IIT - Printed and Molecular Electronics group (PME)
The Printed and Molecular Electronics group works on solution-processable and sustainable semiconductors, in particular conjugated organic materials, taking full advantage of their printability in order to deliver applications in the large-area and flexible electronics fields. Current research activities include: edible electronics, where electronic properties of food stuff is leveraged to develop smart edible pills for medical applications as well sensors for food quality monitoring; electronic systems that can be digested or even metabolized in the body; printed organic biosensors, targeting large-area devices for electrophysiology as well as rapid diagnostic and point-of-care applications; printed organic transistors operating at Radio Frequencies, for wireless printed sensors and IoT; printed organic thermoelectric generators, as cost-effective and sustainable waste heat energy harvesters.
Key Contribution
Key People


Electronic Design Laboratory
The Electronic Design Laboratory specializes in the development of flexible electronic devices optimized for a high Technology Readiness Level (TRL). EDL possesses a comprehensive set of validation equipment, including development kits, rapid prototyping machines, and a CAD lab for designing printed circuit boards and integrated circuits. These resources enable the creation of advanced electronic platforms, covering applications related to advanced motor control, read-out and signal conditioning systems, data transmission systems, and low-power wireless systems, among others.
Key Contribution
Key People






National Research Council - CNR
Institute of Clinical Physiology (CNR-IFC)
IFC operates in the context of the Department of Biomedicine and is the largest biomedical institute of CNR. CNR-IFC holds a privileged position in research and higher education. The main areas of research are: 1) Bio-Techno-Science and Modelling, 2) Preclinical Biology and Mechanism of Disease, 3) Clinical Pathophysiology and Health Risk Factors, and 4) Epidemiology and Health Promotion. This multidisciplinary approach is the key element of a strategy that promotes collaborations in a flexible and problem-solving way and sets the “personalized care” as a goal, to guarantee social health and optimal life quality.
Key Contribution
Key People
Platelet aggregation
Vascular endothelial activation


Echocardiographic quantitative imaging

The Institute of Materials for Electronics and Magnetism (CNR-IMEM)
IMEM develops interdisciplinary research approaches in the field of Materials Science, including advanced methods of synthesis and characterization as well as device manufacturing technologies, designed with the aim of exploring functional properties of the materials themselves. The main research areas are: 1) Materials and technologies for green energy; 2) Sensors for IOT and sustainable development; 3) Smart and neuromorphic bio-interfacing systems; 4) Magnetic and multiferroic materials; 5) growth-of-nanostructured-and-functional-materials; structural and surface characterization.
Key Contribution
The organic electronics laboratory of IMEM-CNR, the BioTechTronics Lab (https://twitter.com/BioIMEM), will contribute to the IV-Lab project in the design and manufacturing of an electrochemical sensor of Troponins, target molecules for heart failure, based on organic active materials and made by advanced printing technologies. In IMEM the sensor engine will be realized in a transistor architecture and in a 3-terminal layout, by chemically modifying the electrodes with antibody functionalization. The sensor will be whole printed and made of biocompatible organic printable ink-materials.
Key People


Trinity College Dublin – TCD
Florea and Delaney Labs
Key Contribution
Key People

Institute for Bioengineering of Catalonia - IBEC
Nanobioengineering group
Key Contribution
Development of electrochemical sensor based on solid-state ion selective electrode (ISE) for detection of electrolytes and electrochemical aptamer based beacon sensors for heart failure biomarkers; IV-Lab specification definition.
development of nano-coating for emo-compatibilization; emo-compatibility tests. Key persons: César Rodriguez-Emmenegger (PI)
Key People



Bioinspired Interactive Materials and Protocellular Systems group
The Bioinspired Interactive Materials and Protocellular Systems group at IBEC primarily focuses on macromolecular engineering, adaptive interfaces, and synthetic biomembranes, with the potential to build synthetic cells. One of the lab's key interests is the development of adaptive coatings that can interact and direct the biological surroundings in a self-regulated manner and their translation to medical and diagnostic applications. The use of such nanoscale 'invisible' coatings protects surfaces against molecular fouling and bacterial colonization, also allowing the decoration of the surfaces with biomolecules and create feedback loops with the surrounding environment.
Key Contribution
Key People

University of Stuttgart - USTUTT
4th Physics Institute
Key Contribution
Key People



